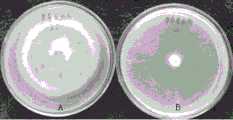
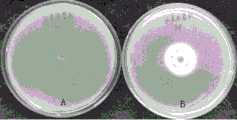
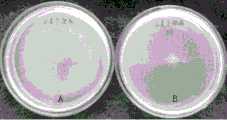
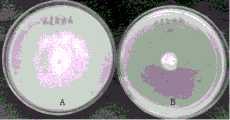
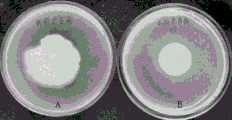

CN108441453B - Saraca pseudomonas with broad-spectrum antibacterial activity and application thereof - Google Patents
Saraca pseudomonas with broad-spectrum antibacterial activity and application thereofDownload PDFInfo
- Publication number
- CN108441453B CN108441453BCN201810442369.6ACN201810442369ACN108441453BCN 108441453 BCN108441453 BCN 108441453BCN 201810442369 ACN201810442369 ACN 201810442369ACN 108441453 BCN108441453 BCN 108441453B
- Authority
- CN
- China
- Prior art keywords
- pseudomonas
- wheat
- skl108
- broad
- saraca
- Prior art date
- Legal status (The legal status is an assumption and is not a legal conclusion. Google has not performed a legal analysis and makes no representation as to the accuracy of the status listed.)
- Active
Links
- 241000589516PseudomonasSpecies0.000titleclaimsabstractdescription61
- 230000000844anti-bacterial effectEffects0.000titleclaimsabstractdescription14
- 241000350490SaracaSpecies0.000titleclaimsdescription10
- 241000209140TriticumSpecies0.000claimsabstractdescription34
- 235000021307TriticumNutrition0.000claimsabstractdescription34
- 201000010099diseaseDiseases0.000claimsabstractdescription31
- 208000037265diseases, disorders, signs and symptomsDiseases0.000claimsabstractdescription31
- 235000007164Oryza sativaNutrition0.000claimsabstractdescription23
- 235000009566riceNutrition0.000claimsabstractdescription23
- 235000007688Lycopersicon esculentumNutrition0.000claimsabstractdescription19
- 240000003768Solanum lycopersicumSpecies0.000claimsabstractdescription19
- 235000016623Fragaria vescaNutrition0.000claimsabstractdescription13
- 235000011363Fragaria x ananassaNutrition0.000claimsabstractdescription13
- 206010039509ScabDiseases0.000claimsabstractdescription11
- 235000009754Vitis X bourquinaNutrition0.000claimsabstractdescription11
- 235000012333Vitis X labruscanaNutrition0.000claimsabstractdescription11
- 235000014787Vitis viniferaNutrition0.000claimsabstractdescription11
- 238000004321preservationMethods0.000claimsabstractdescription11
- 240000007594Oryza sativaSpecies0.000claimsabstract6
- 240000009088Fragaria x ananassaSpecies0.000claimsabstract3
- 240000006365Vitis viniferaSpecies0.000claimsabstract3
- 241000196324EmbryophytaSpecies0.000claimsdescription9
- 239000007788liquidSubstances0.000claimsdescription8
- 241001237745SalamisSpecies0.000claims1
- 235000015175salamiNutrition0.000claims1
- 244000052616bacterial pathogenSpecies0.000abstractdescription12
- 230000002401inhibitory effectEffects0.000abstractdescription12
- 230000000443biocontrolEffects0.000abstractdescription4
- 244000005700microbiomeSpecies0.000abstractdescription4
- 239000003899bactericide agentSubstances0.000abstractdescription3
- 238000011161developmentMethods0.000abstractdescription3
- 238000009629microbiological cultureMethods0.000abstractdescription3
- 230000002045lasting effectEffects0.000abstractdescription2
- 241001216686Pseudomonas helmanticensisSpecies0.000abstract1
- 239000002068microbial inoculumSubstances0.000abstract1
- 238000012360testing methodMethods0.000description28
- 241000209094OryzaSpecies0.000description17
- 230000001580bacterial effectEffects0.000description13
- 230000005764inhibitory processEffects0.000description11
- 241000220223FragariaSpecies0.000description10
- 241000219095VitisSpecies0.000description8
- 230000000694effectsEffects0.000description7
- 239000002689soilSubstances0.000description7
- 239000000725suspensionSubstances0.000description7
- XLYOFNOQVPJJNP-UHFFFAOYSA-NwaterSubstancesOXLYOFNOQVPJJNP-UHFFFAOYSA-N0.000description7
- 241000894006BacteriaSpecies0.000description6
- 230000003042antagnostic effectEffects0.000description5
- 239000001963growth mediumSubstances0.000description5
- 238000000034methodMethods0.000description5
- 239000003795chemical substances by applicationSubstances0.000description4
- 238000012258culturingMethods0.000description4
- 238000002474experimental methodMethods0.000description4
- 230000012010growthEffects0.000description4
- 10802000446516S ribosomal RNAProteins0.000description3
- 239000005747ChlorothalonilSubstances0.000description3
- CRQQGFGUEAVUIL-UHFFFAOYSA-NchlorothalonilChemical compoundClC1=C(Cl)C(C#N)=C(Cl)C(C#N)=C1ClCRQQGFGUEAVUIL-UHFFFAOYSA-N0.000description3
- KRKNYBCHXYNGOX-UHFFFAOYSA-Ncitric acidChemical compoundOC(=O)CC(O)(C(O)=O)CC(O)=OKRKNYBCHXYNGOX-UHFFFAOYSA-N0.000description3
- 230000000813microbial effectEffects0.000description3
- 239000000575pesticideSubstances0.000description3
- 238000011160researchMethods0.000description3
- 238000012216screeningMethods0.000description3
- 229920001817AgarPolymers0.000description2
- 241000123650Botrytis cinereaSpecies0.000description2
- 241000269333CaudataSpecies0.000description2
- 241000233866FungiSpecies0.000description2
- 241000589517Pseudomonas aeruginosaSpecies0.000description2
- FAPWRFPIFSIZLT-UHFFFAOYSA-MSodium chlorideChemical compound[Na+].[Cl-]FAPWRFPIFSIZLT-UHFFFAOYSA-M0.000description2
- 239000008272agarSubstances0.000description2
- 238000012271agricultural productionMethods0.000description2
- 230000003115biocidal effectEffects0.000description2
- 239000011248coating agentSubstances0.000description2
- 238000000576coating methodMethods0.000description2
- 238000007865dilutingMethods0.000description2
- 244000053095fungal pathogenSpecies0.000description2
- 230000003902lesionEffects0.000description2
- 239000000203mixtureSubstances0.000description2
- 244000052769pathogenSpecies0.000description2
- 230000001717pathogenic effectEffects0.000description2
- 108090000623proteins and genesProteins0.000description2
- 238000000746purificationMethods0.000description2
- 239000008223sterile waterSubstances0.000description2
- 239000000126substanceSubstances0.000description2
- 239000004475ArginineSubstances0.000description1
- 102000016938CatalaseHuman genes0.000description1
- 108010053835CatalaseProteins0.000description1
- 241001290235Ceratobasidium cerealeSpecies0.000description1
- 206010059866Drug resistanceDiseases0.000description1
- 241000223195Fusarium graminearumSpecies0.000description1
- WQZGKKKJIJFFOK-GASJEMHNSA-NGlucoseNatural productsOC[C@H]1OC(O)[C@H](O)[C@@H](O)[C@@H]1OWQZGKKKJIJFFOK-GASJEMHNSA-N0.000description1
- 238000003794Gram stainingMethods0.000description1
- 241000238631HexapodaSpecies0.000description1
- 239000012880LB liquid culture mediumSubstances0.000description1
- 102000004316OxidoreductasesHuman genes0.000description1
- 108090000854OxidoreductasesProteins0.000description1
- 241000589540Pseudomonas fluorescensSpecies0.000description1
- 241000589615Pseudomonas syringaeSpecies0.000description1
- 241000813090Rhizoctonia solaniSpecies0.000description1
- 238000012300Sequence AnalysisMethods0.000description1
- 244000061456Solanum tuberosumSpecies0.000description1
- 235000002595Solanum tuberosumNutrition0.000description1
- 241000191940StaphylococcusSpecies0.000description1
- 208000025865UlcerDiseases0.000description1
- 241001474928Ustilaginoidea virensSpecies0.000description1
- 241000607479Yersinia pestisSpecies0.000description1
- 239000003905agrochemicalSubstances0.000description1
- ODKSFYDXXFIFQN-UHFFFAOYSA-NarginineNatural productsOC(=O)C(N)CCCNC(N)=NODKSFYDXXFIFQN-UHFFFAOYSA-N0.000description1
- 230000001420bacteriolytic effectEffects0.000description1
- 230000003385bacteriostatic effectEffects0.000description1
- 238000010009beatingMethods0.000description1
- 230000009286beneficial effectEffects0.000description1
- WQZGKKKJIJFFOK-FPRJBGLDSA-Nbeta-D-galactoseChemical compoundOC[C@H]1O[C@@H](O)[C@H](O)[C@@H](O)[C@H]1OWQZGKKKJIJFFOK-FPRJBGLDSA-N0.000description1
- 229940041514candida albicans extractDrugs0.000description1
- 239000003153chemical reaction reagentSubstances0.000description1
- 238000010367cloningMethods0.000description1
- 238000001514detection methodMethods0.000description1
- 239000003085diluting agentSubstances0.000description1
- 238000009328dry farmingMethods0.000description1
- 238000003912environmental pollutionMethods0.000description1
- 238000000855fermentationMethods0.000description1
- 230000004151fermentationEffects0.000description1
- 239000003337fertilizerSubstances0.000description1
- 239000008103glucoseSubstances0.000description1
- 230000006698inductionEffects0.000description1
- 208000015181infectious diseaseDiseases0.000description1
- 238000011081inoculationMethods0.000description1
- 230000006799invasive growth in response to glucose limitationEffects0.000description1
- 244000144972livestockSpecies0.000description1
- 230000007774longtermEffects0.000description1
- 238000012423maintenanceMethods0.000description1
- 239000002207metaboliteSubstances0.000description1
- 238000002156mixingMethods0.000description1
- 238000012986modificationMethods0.000description1
- 230000004048modificationEffects0.000description1
- 230000000877morphologic effectEffects0.000description1
- 235000016709nutritionNutrition0.000description1
- 230000003071parasitic effectEffects0.000description1
- 239000000447pesticide residueSubstances0.000description1
- 230000002265preventionEffects0.000description1
- 108700022487rRNA GenesProteins0.000description1
- 238000000926separation methodMethods0.000description1
- 239000011780sodium chlorideSubstances0.000description1
- 238000009331sowingMethods0.000description1
- 241000894007speciesSpecies0.000description1
- 238000005507sprayingMethods0.000description1
- 239000012137tryptoneSubstances0.000description1
- 231100000397ulcerToxicity0.000description1
- 238000005303weighingMethods0.000description1
- 239000012138yeast extractSubstances0.000description1
Images
Classifications
- C—CHEMISTRY; METALLURGY
- C12—BIOCHEMISTRY; BEER; SPIRITS; WINE; VINEGAR; MICROBIOLOGY; ENZYMOLOGY; MUTATION OR GENETIC ENGINEERING
- C12N—MICROORGANISMS OR ENZYMES; COMPOSITIONS THEREOF; PROPAGATING, PRESERVING, OR MAINTAINING MICROORGANISMS; MUTATION OR GENETIC ENGINEERING; CULTURE MEDIA
- C12N1/00—Microorganisms, e.g. protozoa; Compositions thereof; Processes of propagating, maintaining or preserving microorganisms or compositions thereof; Processes of preparing or isolating a composition containing a microorganism; Culture media therefor
- C12N1/20—Bacteria; Culture media therefor
- C12N1/205—Bacterial isolates
- C—CHEMISTRY; METALLURGY
- C12—BIOCHEMISTRY; BEER; SPIRITS; WINE; VINEGAR; MICROBIOLOGY; ENZYMOLOGY; MUTATION OR GENETIC ENGINEERING
- C12R—INDEXING SCHEME ASSOCIATED WITH SUBCLASSES C12C - C12Q, RELATING TO MICROORGANISMS
- C12R2001/00—Microorganisms ; Processes using microorganisms
- C12R2001/01—Bacteria or Actinomycetales ; using bacteria or Actinomycetales
- C12R2001/38—Pseudomonas
- A—HUMAN NECESSITIES
- A01—AGRICULTURE; FORESTRY; ANIMAL HUSBANDRY; HUNTING; TRAPPING; FISHING
- A01N—PRESERVATION OF BODIES OF HUMANS OR ANIMALS OR PLANTS OR PARTS THEREOF; BIOCIDES, e.g. AS DISINFECTANTS, AS PESTICIDES OR AS HERBICIDES; PEST REPELLANTS OR ATTRACTANTS; PLANT GROWTH REGULATORS
- A01N63/00—Biocides, pest repellants or attractants, or plant growth regulators containing microorganisms, viruses, microbial fungi, animals or substances produced by, or obtained from, microorganisms, viruses, microbial fungi or animals, e.g. enzymes or fermentates
- A01N63/10—Animals; Substances produced thereby or obtained therefrom
Landscapes
- Life Sciences & Earth Sciences (AREA)
- Engineering & Computer Science (AREA)
- Health & Medical Sciences (AREA)
- Zoology (AREA)
- Chemical & Material Sciences (AREA)
- Organic Chemistry (AREA)
- General Health & Medical Sciences (AREA)
- Wood Science & Technology (AREA)
- Microbiology (AREA)
- Genetics & Genomics (AREA)
- Bioinformatics & Cheminformatics (AREA)
- Biotechnology (AREA)
- Biochemistry (AREA)
- General Engineering & Computer Science (AREA)
- Virology (AREA)
- Environmental Sciences (AREA)
- Pest Control & Pesticides (AREA)
- Dentistry (AREA)
- Plant Pathology (AREA)
- Agronomy & Crop Science (AREA)
- Medicinal Chemistry (AREA)
- Tropical Medicine & Parasitology (AREA)
- Biomedical Technology (AREA)
- Agricultural Chemicals And Associated Chemicals (AREA)
- Micro-Organisms Or Cultivation Processes Thereof (AREA)
Abstract
Description
Technical Field
The invention relates to the field of biotechnology, in particular to pseudomonas SKL108 with broad-spectrum antibacterial activity and application of the strain in disease control of field and economic crops.
Background
In a natural ecosystem in the field, crops face the infection threat of various pathogenic bacteria, the variety and cultivation modes of the crops are diversified, so that the crop diseases become serious day by day, the traditional control method in China mainly depends on chemical pesticides at present, but the traditional control method in China generates drug resistance after long-term use, the pesticide residue seriously pollutes agricultural products and the environment, the health of people and livestock is threatened, the sustainable development of agricultural production is restricted, and the method becomes one of the current serious social problems. Therefore, the beneficial microorganisms are utilized to prevent and control crop diseases and insect pests and improve crop yield, and the research hotspot is formed. Microbial control is one of biological control, and it utilizes the interrelation among biological species, such as competition, antibiotic, parasitic, bacteriolytic and induction resistance, etc., to inhibit the growth of pathogenic fungi with live bacteria or products thereof, and has the advantages of no environmental pollution, safety to human and other organisms, no residue in products, energy saving and ecological balance maintenance, etc., and in view of this, broad-spectrum and efficient biological bactericides are urgently needed to be developed.
In recent years, the study of soil microorganisms has become a focus, among which pseudomonas plays an important role in the biological control of crop diseases, and it can inhibit the growth of pathogenic bacteria through nutritional competition and antibiotic action of metabolites. In China, the biocontrol pseudomonas for preventing and treating crop pathogenic bacteria mainly comprises pseudomonas fluorescens, pseudomonas aeruginosa, pseudomonas syringae, pseudomonas aeruginosa and the like, and at present, no report is found for antagonizing field and economic crop pathogenic fungi in the Saraca pseudomonas.
Disclosure of Invention
In order to solve the problems, the applicant separates a pseudomonas SKL108 with broad-spectrum antibacterial activity from the soil of Nanjing purple Jinshan, and finds that the pseudomonas belongs to the pseudomonas of Saraca through 16s rRNA cloning and sequence analysis, and has the broad-spectrum antibacterial activity.
The invention firstly provides a strain of Pseudomonas saramansii (Pseudomonas hellmentiensis) preserved in China general microbiological culture Collection center (CGMCC for short), wherein the preservation unit address is as follows: western road No.1, north west city of township, beijing, institute of microbiology, china academy of sciences; the preservation number is CGMCC No.15571, and the preservation date is 2018, 4 months and 9 days.
The applicant self-names the pseudomonas samarancacai as SKL108, and the morphological characteristics of the pseudomonas samarancacai are as follows: the thallus is rod-shaped, gram staining is negative, VP experiment is positive, arginine double hydrolase and citric acid can be hydrolyzed, beta-galactose glycase can not be hydrolyzed, and oxidase and catalase experiments are positive.
The invention further provides application of the Saraca pseudomonas with the preservation number of CGMCC No.15571 in inhibiting pathogenic bacteria such as rice sheath blight, false smut, rice bakanae disease, wheat scab, wheat sheath blight, wheat take-all, tomato gray mold, strawberry anthracnose, grape canker and the like.
Specifically, the above applications refer to: when the crop diseases occur sporadically, the Saraca pseudomonas is configured to have the bacterial content of about 1010Diluting cfu/ml bacterial solution or microbial agent by 500 times, and mixing at a ratio of 15ml/m2The pesticide is uniformly sprayed on the leaf surfaces of field plants, and is sprayed once again with the same dosage after 10 days, and is continuously used for 3 times to prevent and treat crop rice sheath blight, false smut, rice bakanae disease, wheat scab, wheat sharp eyespot, wheat take-all, tomato gray mold, strawberry anthracnose and grape canker.
Compared with the prior art, the Pseudomonas samarangani (Pseudomonas) provided by the application
Helmanticensis) SKL108 strain can effectively inhibit the growth of pathogenic bacteria such as rice sheath blight, false smut, rice bakanae disease, wheat scab, wheat sheath blight, wheat take-all, tomato gray mold, strawberry anthracnose, grape canker and the like, makes up the blank of the strain in agricultural production, and provides a new way for the prevention and treatment of biological pesticides. The biocontrol strain has lasting and stable antibacterial effect, has great potential for developing novel, efficient and broad-spectrum biocontrol bactericide, and provides a new way for the development of applying microorganisms to biological control.
Drawings
FIG. 1 is a schematic representation of the phylogenetic tree of Pseudomonas SKL10816S rRNA gene.
FIG. 2 is a control test picture of Pseudomonas SKL108 inhibiting Rhizoctonia solani, wherein FIG. 2A is a blank control test picture, and FIG. 2B is a Pseudomonas SKL108 zone of inhibition picture.
FIG. 3 is a control test picture of Pseudomonas SKL108 for inhibiting Ustilaginoidea virens, wherein FIG. 3A is a blank control test picture, and FIG. 3B is a picture of Pseudomonas SKL108 zone of inhibition.
FIG. 4 is a comparison test picture of Pseudomonas SKL108 inhibiting rice bakanae disease, wherein FIG. 4A is a blank comparison test picture, and FIG. 4B is a Pseudomonas SKL108 zone of inhibition picture.
Fig. 5 is a control test picture of pseudomonas SKL108 inhibiting fusarium graminearum, wherein fig. 5A is a blank control test picture, and fig. 5B is a pseudomonas SKL108 zone of inhibition picture.
Fig. 6 is a control test picture of pseudomonas SKL108 inhibiting rhizoctonia cerealis, wherein fig. 6A is a blank control test picture, and fig. 6B is a pseudomonas SKL108 zone of inhibition picture.
Fig. 7 is a control test picture of pseudomonas SKL108 inhibiting wheat take-all pathogen, wherein fig. 7A is a blank control test picture, and fig. 7B is a pseudomonas SKL108 zone of inhibition picture.
FIG. 8 is a control test picture of Pseudomonas SKL108 inhibiting Botrytis cinerea, wherein FIG. 8A is a blank control test picture, and FIG. 8B is a Pseudomonas SKL108 zone of inhibition picture.
Fig. 9 is a comparison test picture of pseudomonas SKL108 inhibiting botrytis cinerea, wherein fig. 9A is a blank comparison test picture, and fig. 9B is a pseudomonas SKL108 zone of inhibition picture.
Fig. 10 is a control test picture of pseudomonas SKL108 inhibiting strawberry anthracnose pathogen, wherein fig. 10A is a blank control test picture, and fig. 10B is a pseudomonas SKL108 zone of inhibition picture.
Fig. 11 is a control test picture of pseudomonas SKL108 inhibiting staphylococcus ulcer germs, wherein fig. 11A is a blank control test picture, and fig. 11B is a pseudomonas SKL108 zone of inhibition picture.
Detailed Description
The invention is further illustrated by the following examples, which are not intended to limit the scope of the invention.
Pathogenic bacteria of rice sheath blight disease, false smut and bakanae disease of rice related to the following examples are provided by plant protection institute of agricultural academy of Jiangsu province; pathogenic bacteria of wheat scab, wheat sharp eyespot, wheat take-all and tomato gray mold are provided by a dry farming disease research laboratory of the plant protection institute of the agricultural academy of Jiangsu province; pathogenic bacteria of strawberry gray mold, strawberry anthracnose and grape canker are provided by ecological agriculture research laboratories of Zhenjiang agricultural departments.
PDA culture medium: 200g of peeled potato, 10g of glucose, 20g of agar and 1L of water;
the reagents referred to in the examples are all commercially available products.
Example 1
1. Obtaining of Pseudomonas SKL108 Strain
1) Separation, purification and preservation of strains
Weighing 10g of soil randomly collected from the purple Jinshan mountain of Nanjing City, Jiangsu province, adding the soil into a triangular flask containing 90ml of sterile water, carrying out shake culture for 30min (150r/min) to prepare a suspension with a ratio of 1:10 (soil: water), then taking 1ml of the suspension into 9ml of sterile water to prepare a 10-2 diluted suspension, repeating the steps in the same manner to prepare 10-5 and 10-6 diluted suspensions, sucking 200ul of the diluted suspensions, adding the diluted suspensions into LB culture medium (10 g of tryptone, 5g of yeast extract, 10g of sodium chloride, 20g of agar, 1L of water and pH7.0) plates, uniformly coating the diluted suspensions with a coating rod, repeating the treatment for 3 times, and placing the culture dish in a constant temperature incubator at 28 ℃ for culture for 2-3 d.
Selecting single colony according to the characteristics of colony morphology, color and the like, transferring the single colony to an LB liquid culture medium for culture, and screening the strain with good antagonistic effect by adopting a plate opposite method. Culturing rice sheath blight, false smut, rice bakanae disease, wheat scab, wheat sharp eyespot, wheat take-all, tomato gray mold, strawberry anthracnose and grape canker on a special culture medium, beating a bacterium block at the edge of a flat plate by a puncher after the bacterium grows over the flat plate, placing the bacterium block in the center of another flat plate, inoculating pseudomonas at intervals of 2.5cm along four directions around the bacterium block, placing the bacterium block in an incubator at 25 ℃ for culturing, and evaluating the antagonistic effect of the strain according to the size of a bacteriostatic circle after primary screening and secondary screening.
2) Identification and preservation of strains
The bacterial strain with better antagonistic effect is obtained after the purification and culture of the bacterial strain, the applicant sends the bacterial strain with the name of SKL108 to the institute of microbiology of academy of sciences of China for detection and identification, the identification result is Pseudomonas salamander (Pseudomonas palmmentensis) of Pseudomonas, and the bacterial strain is frozen and stored with original bacterial strain. The invention relates to a Pseudomonas Salamans SKL108 strain preserved in the China general microbiological culture Collection center, with the preservation number: CGMCC No.15571, and the preservation date is 4 months and 9 days in 2018.
The physical and chemical properties of the strain are as follows:
1) the cell morphology and the results of physicochemical experiments of SKL108 strain are shown in Table 1
TABLE 1 results of cell morphology and physicochemical experiments
2) The 16S rRNA gene sequence of the SKL108 strain is shown in SEQ ID NO.1, and the phylogenetic tree of the 16S rRNA gene is shown in figure 1.
2. Determination of broad-spectrum antibacterial activity of pseudomonas SKL108 strain
Pathogenic bacteria of rice sheath blight, false smut, rice bakanae disease, wheat scab, wheat sharp eyespot, wheat take-all, tomato gray mold, strawberry anthracnose and grape canker are beaten into fungus cakes with the diameter of 5mm by a puncher and are placed in the middle of a PDA culture medium plate, 5 mul of pseudomonas SKL108 fungus liquid is inoculated around by adopting a cross method, a blank control is set, and the bacteriostasis effect is shown in the attached figure 2-the attached figure 11 and the table 2:
TABLE 2 size of the zone of inhibition of Pseudomonas SKL108 against pathogenic bacteria of field and commercial crops
Therefore, the strain has better antagonistic action on rice sheath blight disease, false smut, rice bakanae disease, wheat scab, wheat sheath blight, wheat take-all, tomato gray mold, strawberry anthracnose and grape canker.
Example 2 potted plant control test of tomato gray mold with pseudomonas samaranca SKL108 bacterial liquid.
Test time: in 2017, 10 months in a greenhouse of agricultural institute of Jiangsu province.
The test varieties are as follows: ju fen bao.
Test agents: culturing Pseudomonas saracani SKL108 bacterial liquid in laboratory shaking table (LB culture medium, 28 deg.C, 160r/min) for 2d, and culturing to obtain bacterial content of about 1010cfu/ml。
The control agent was 75% chlorothalonil (Nippon Caoda Co., Ltd.).
Potted plant control effect test: sowing the giant pink tomato in the sterilized soil, and transplanting and planting when 6 true leaves grow out from the tomato seedlings.
Gray mold control test: transplanting the seedlings into pots filled with sterile soil, 1 plant per pot. Artificially spraying spore liquid of gray mold, and after 2d, diluting bacterial liquid with 500 times of SKL108 by 15ml/m2The dosage of the fertilizer is uniformly sprayed on tomato seedlings. And (4) treating 20 pots each time and performing conventional management. Clear water and 800 times of chlorothalonil diluent (effective dosage is 0.15 g/m)2) As a control, the disease condition was adjusted after 21 days of growth, and the control effect was calculated.
Grading standard of diseased leaves: level 0: no disease spots; and (l) grade: the lesion spots account for less than 5% of the leaf area; and 3, level: the disease spots occupy 6-15% of the leaf area; and 5, stage: the disease spots account for 16-25% of the leaf area; and 7, stage: the disease spots account for 26-50% of the leaf area; and 9, stage: the lesion spots account for more than 50% of the leaf area.
Disease index ═ number of onset of disease at each stage × representative value at each stage)/(total number of investigated plants × highest representative value) ] × 100
Control effect (%) < control disease index > < 100%
The test results are shown in table 3:
TABLE 3 potted plant test control of tomato gray mold by Pseudomonas saracani SKL108 bacterial liquid
It can be seen that the index of disease of gray mold of tomato in the clear water control after artificial inoculation is 38.25. The control effect of the pseudomonas samarangensis SKL108 bacterial liquid on the tomato gray mold is 69.1%. The control effect of chlorothalonil on the tomato gray mold is 60.7 percent, which is obviously lower than the control effect of pseudomonas salamander SKL 108.
In specific practice, when various diseases of crops occur sporadically, the strain fermentation liquor or prepared microbial agent is diluted by 500 times and then is mixed according to the proportion of 15ml/m2The dosage of the composition is uniformly applied to crops, and the composition is sprayed for 3 times at intervals of 10 days for preventing and treating rice sheath blight, false smut, rice bakanae disease, wheat scab, wheat sheath blight, wheat take-all, tomato gray mold, strawberry anthracnose and grape canker.
The above description is only a preferred embodiment of the present invention and should not be taken as limiting the invention, but rather several modifications and amendments are possible without deviating from the principle of the present invention, as long as they are within the scope defined by the claims.
Sequence listing
<110> Suke agro-chemical Limited liability company of Jiangsu province
<120> Saraca pseudomonas with broad-spectrum antibacterial activity and application thereof
<141> 2018-05-10
<160> 1
<170> SIPOSequenceListing 1.0
<210> 1
<211> 1348
<212> DNA
<213> Pseudomonas helmanciensis (Pseudomonas helmantensis)
<400> 1
tacttctggt gcaacccact cccatggtgt gacgggcggt gtgtacaagg cccgggaacg 60
tattcaccgc gacattctga ttcgcgatta ctagcgattc cgacttcacg cagtcgagtt 120
gcagactgcg atccggacta cgatcggttt tatgggatta gctccacctc gcggcttggc 180
aaccctttgt accgaccatt gtagcacgtg tgtagcccag gccgtaaggg ccatgatgac 240
ttgacgtcat ccccaccttc ctccggtttg tcaccggcag tctccttaga gtgcccacca 300
taacgtgctg gtaactaagg acaagggttg cgctcgttac gggacttaac ccaacatctc 360
acgacacgag ctgacgacag ccatgcagca cctgtctcaa tgttcccgaa ggcaccaatc 420
catctctgga aagttcattg gatgtcaagg cctggtaagg ttcttcgcgt tgcttcgaat 480
taaaccacat gctccaccgc ttgtgcgggc ccccgtcaat tcatttgagt tttaaccttg 540
cggccgtact ccccaggcgg tcaacttaat gcgttagctg cgccactaag agctcaaggc 600
tcccaacggc tagttgacat cgtttacggc gtggactacc agggtatcta atcctgtttg 660
ctccccacgc tttcgcacct cagtgtcagt atcagtccag gtggtcgcct tcgccactgg 720
tgttccttcc tatatctacg catttcaccg ctacacagga aattccacca ccctctacca 780
tactctagct cgccagtttt ggatgcagtt cccaggttga gcccggggat ttcacatcca 840
acttaacgaa ccacctacgc gcgctttacg cccagtaatt ccgattaacg cttgcaccct 900
ctgtattacc gcggctgctg gcacagagtt agccggtgct tattctgtcg gtaacgtcaa 960
aacagcaaag tattaattta ctgcccttcc tcccaactta aagtgcttta caatccgaag 1020
accttcttca cacacgcggc atggctggat caggctttcg cccattgtcc aatattcccc 1080
actgctgcct cccgtaggag tctggaccgt gtctcagttc cagtgtgact gatcatcctc 1140
tcagaccagt tacggatcgt cgccttggtg agccattacc tcaccaacta gctaatccga 1200
cctaggctca tctgatagcg caaggcccga aggtcccctg ctttctcccg taggacgtat 1260
gcggtattag cgttcctttc gaaacgttgt cccccactac caggcagatt cctaggcatt 1320
actcacccgt ccgccgctga attcagga 1348
Claims (3)
1. Pseudomonas saraca (a strain of Saraca) with broad-spectrum antibacterial activityPseudomonas helmanticensis) The preservation number is CGMCC No. 15571.
2. The use of pseudomonas salami of claim 1 for controlling rice sheath blight, false smut, rice bakanae disease, wheat scab, wheat sheath blight, wheat take-all, tomato gray mold, strawberry anthracnose, and grape canker.
3. The use of claim 2, wherein the use is that the Saraca pseudomonas liquid is sprayed on the leaf surfaces of field plants to prevent rice sheath blight, false smut, rice bakanae disease, wheat scab, wheat sharp eyespot, wheat take-all, tomato gray mold, strawberry anthracnose and grape canker.
Priority Applications (1)
| Application Number | Priority Date | Filing Date | Title |
|---|---|---|---|
| CN201810442369.6ACN108441453B (en) | 2018-05-10 | 2018-05-10 | Saraca pseudomonas with broad-spectrum antibacterial activity and application thereof |
Applications Claiming Priority (1)
| Application Number | Priority Date | Filing Date | Title |
|---|---|---|---|
| CN201810442369.6ACN108441453B (en) | 2018-05-10 | 2018-05-10 | Saraca pseudomonas with broad-spectrum antibacterial activity and application thereof |
Publications (2)
| Publication Number | Publication Date |
|---|---|
| CN108441453A CN108441453A (en) | 2018-08-24 |
| CN108441453Btrue CN108441453B (en) | 2021-03-19 |
Family
ID=63202880
Family Applications (1)
| Application Number | Title | Priority Date | Filing Date |
|---|---|---|---|
| CN201810442369.6AActiveCN108441453B (en) | 2018-05-10 | 2018-05-10 | Saraca pseudomonas with broad-spectrum antibacterial activity and application thereof |
Country Status (1)
| Country | Link |
|---|---|
| CN (1) | CN108441453B (en) |
Families Citing this family (3)
| Publication number | Priority date | Publication date | Assignee | Title |
|---|---|---|---|---|
| CN111187741B (en)* | 2020-02-21 | 2022-04-08 | 上海交通大学 | Biocontrol pseudomonas and application thereof |
| CN117384806A (en)* | 2023-12-13 | 2024-01-12 | 南京农业大学三亚研究院 | A strain of Pseudomonas chlororaphis that produces volatile antibacterial substances and its application |
| CN117770033A (en)* | 2023-12-28 | 2024-03-29 | 西南科技大学 | Endophyte regulation and control-based technical method for controlling lemon sandy skin disease |
Citations (3)
| Publication number | Priority date | Publication date | Assignee | Title |
|---|---|---|---|---|
| CN105886637A (en)* | 2016-05-11 | 2016-08-24 | 辽宁大学 | Aeromonas sobria specific primer and application thereof in turbot cultivation process |
| CA2993188A1 (en)* | 2015-07-25 | 2017-02-02 | Bioconsortia, Inc. | Agriculturally beneficial microbes, microbial compositions, and consortia |
| CN106434493A (en)* | 2016-12-01 | 2017-02-22 | 北京市农林科学院 | Strain of biocontrol Streptomyces and application thereof |
Family Cites Families (1)
| Publication number | Priority date | Publication date | Assignee | Title |
|---|---|---|---|---|
| CN102199558A (en)* | 2010-08-06 | 2011-09-28 | 上海师范大学 | Culture method and applications of Pseudomonas aurantiaca |
- 2018
- 2018-05-10CNCN201810442369.6Apatent/CN108441453B/enactiveActive
Patent Citations (3)
| Publication number | Priority date | Publication date | Assignee | Title |
|---|---|---|---|---|
| CA2993188A1 (en)* | 2015-07-25 | 2017-02-02 | Bioconsortia, Inc. | Agriculturally beneficial microbes, microbial compositions, and consortia |
| CN105886637A (en)* | 2016-05-11 | 2016-08-24 | 辽宁大学 | Aeromonas sobria specific primer and application thereof in turbot cultivation process |
| CN106434493A (en)* | 2016-12-01 | 2017-02-22 | 北京市农林科学院 | Strain of biocontrol Streptomyces and application thereof |
Non-Patent Citations (3)
| Title |
|---|
| Pseudomonas granadensis sp. nov., a new bacterial species isolated from the Tejeda, Almijara and Alhama Natural Park, Granada, Spain;Javier Pascual et al.;《International Journal of Systematic and Evolutionary Microbiology》;20151231;第65卷;第625-632页* |
| Pseudomonas helmanticensis sp. nov., isolated from forest soil;Martha-Helena Ramirez-Bahena et al.;《International Journal of Systematic and Evolutionary Microbiology》;20141231;第64卷;第2338-2345页* |
| 草莓炭疽病拮抗菌SKL108的分离、鉴定及拮抗活性;刘程程等;《江苏农业科学》;20200520;第48卷(第10期);第125-130页* |
Also Published As
| Publication number | Publication date |
|---|---|
| CN108441453A (en) | 2018-08-24 |
Similar Documents
| Publication | Publication Date | Title |
|---|---|---|
| CN112680382B (en) | Bacillus belgii and application thereof | |
| CN108330089B (en) | A kind of broad-spectrum antibacterial activity Bacillus Velez HNt7 and its preparation method and application | |
| CN108641981B (en) | Biocontrol bacillus identification and application | |
| CN100540656C (en) | A kind of bacillus subtilis and its bacterial agent and application | |
| CN102485880B (en) | A strain of Bacillus amyloliquefaciens and its application | |
| CN108102991B (en) | One plant of Bei Laisi bacillus and its application in prevention and treatment watermelon blight | |
| CN104388356A (en) | Streptomyces sampsonii strain as well as separation method and application thereof | |
| CN113388529B (en) | Endophyte Penicillium ehrlichii of tea tree and application thereof | |
| CN104762223A (en) | Bacillus amyloliquefaciense BA-KA3 and application thereof | |
| CN102433282A (en) | Bacillus subtilis NB12 and culture method and application thereof | |
| CN106479934B (en) | An antagonistic strain of Botrytis cinerea and its screening method and application | |
| CN111040976B (en) | A strain of Bacillus amyloliquefaciens and its application | |
| CN104403970B (en) | A kind of bacillus subtilis and the application in control of plant disease thereof | |
| CN111187741B (en) | Biocontrol pseudomonas and application thereof | |
| KR101667541B1 (en) | New microorganism Bacillus methylotrophicus GH1-13 and Microbial agent and biopesticide containing the same | |
| CN115975875B (en) | A strain of Bacillus velezine with biocontrol effect, bacterial agent, preparation method and application thereof | |
| CN104651260A (en) | Brevibacillus brevis BBC-3 and application thereof as well as preparation method of microbial inoculum of brevibacillus brevis | |
| KR20080045346A (en) | Novel Bacillus subtilis M27 strain and method for controlling plant fungal disease comprising the active ingredient | |
| CN113699065A (en) | Bacillus vallismortis and application thereof | |
| CN108441453B (en) | Saraca pseudomonas with broad-spectrum antibacterial activity and application thereof | |
| CN114774279A (en) | Bacillus subtilis YX72 and application thereof in preventing and treating fusarium root rot of tobacco and promoting growth | |
| KR20190136009A (en) | Strains belonging to the genus Mitsaria and microbial pesticides using the strains | |
| CN116445354A (en) | Pseudomonas friedrisburgh and application thereof in disease prevention | |
| CN114836345B (en) | Bacillus amyloliquefaciens HZ11-4 and application thereof | |
| CN118879556B (en) | Bacillus tropicalis NB379, application thereof and microbial inoculum |
Legal Events
| Date | Code | Title | Description |
|---|---|---|---|
| PB01 | Publication | ||
| PB01 | Publication | ||
| SE01 | Entry into force of request for substantive examination | ||
| SE01 | Entry into force of request for substantive examination | ||
| GR01 | Patent grant | ||
| GR01 | Patent grant |